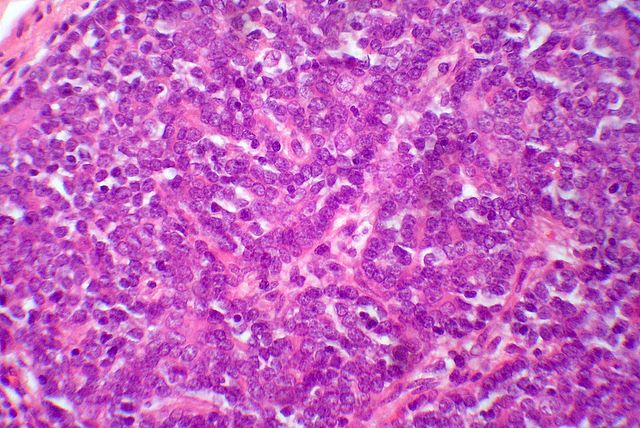

Гистология поджелудочной железы: Функции и структура

Раздел: Альбом идей